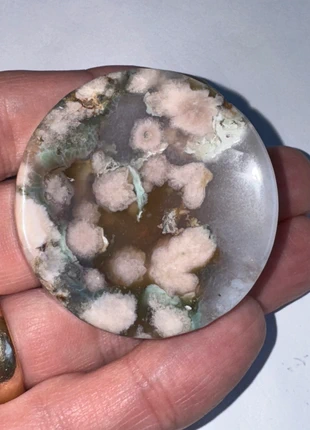
Flower Agate crystal ring trinket dish hand carved and polished stone, brand: Flower Agate crystal, condition: New without tags, £5.00, £5.95 includes Buyer Protection

Items
129 results.
Savfy
New without tags
£4.50
tigerseye
New without tags
£4.95
Sodalite
Very good
£5.75
The Mineral Warehouse Findon
Very good
£5.50
The Mineral Warehouse Findon
Very good
£3.50
Moss agate
Very good
£5.55
tektites
New without tags
£75.00